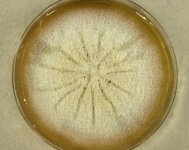

Search Details
| UAMH Number: | 8520 |
|---|---|
| Species Name: | Muyocopron laterale |
| Type: | |
| Synonyms: | Mycoleptodiscus lateralis / Mycoleptodiscus unilateralis / Mycoleptodiscus variabilis |
| Taxonomy: | FUNGI Ascomycota, Dothideomycetes, Muyocopronales, Muyocopronaceae |
| Strain History: | Ramani, R. (244-95) -> UAMH |
| Substrate: | hand and foot, patient on cancer chemotherapy with fatal lymphoma, histopathology preparations positive for fungal elements at both sites | Location: | UNKNOWN (GEO: ?,?) |
| Isolator: | |
| Isolation Date: | 1995 |
| Date Received: | 1996-06-24 |
| Characters: | CULTURE CONDITIONS no conidia observed - // HUMAN/ ANIMAL PATHOGEN subcutaneous lesion in hand & foot - // MOLECULAR SYSTEMATICS 99% ITS similarity among UAMH 8516, 8520 and 10746 - Dewar CL, Sigler L, Clinical Rheumatology 29:1061-1065, 2010 // THERMOTOLERANT grows @ 37C - (Click for publications citing UAMH 8520) |
| Compounds: | |
| Cross Reference: | UTMB 4088 |
| Collections: | Living Strains; Dried Herbarium Material |
| Pathogenic Potential: | Human: no | Animal: no | Plant: no |
| Biosafety Risk Group: | RG1 (check the PHAC ePATHogen Risk Group Database for updates) |
| Regulatory Requirements: | Canadian requesters must provide PHAC Pathogen and Toxin License Number (see: https://www.canada.ca/en/public-health/services/laboratory-biosafety-biosecurity/licensing-program.html) prior to shipment. International requesters must provide all legally required importation documentation prior to shipment. Plant pathogenicity status may be verified by using the USDA Agricultural Research Service (ARS) Fungal Database |
| MycoBank ID: | 828986 |
| Sequences: | >UAMH08520_GU980695_LSU CTGAACTTAAGCATATCAATAAGCGGAGGAAAAGAAACCAACAGGGATTGCCTTAGTAACGGCGAGTGAAGCGGCAACAGCTCAAATTTGAAATCTGGCGTCTTTGGCGTCCGAGTTGTAATTTGCAGAGGATGCTTCGGCGTTGGCGCCGCCCAAAGTTCCTTGGAACGGGACGTCGCAGAGGGTGAGAGCCCCGTGTTCGGGCGGATGCCTTCGCCGTGTGAAGCTCCTTCGACGAGTCGAGTTGTTTGGGAATGCAGCTCAAAACGGGAGGTAAATTTCTTCCAAAGCTAAATACCGGCCGGAGACCGATAGTGCACAAGTAGAGTGATCGAAAGATGAAAAGCACTTTGGAAAGAGAGTCAAACAGCGCGTGAAATTGTTAAAAGGGAAGCGCTTGCGGTCAGAACTTGGCCGCCGTTGCTCGGGGAGGTCTTGCGCCTCCCTCGCTCTTCGGCGGCTGGGCCAGCATCGGTTCGGGCGGCTCGAGAAAGGTCGCGGGAATGTAGCTCCCTCCGGGGAGTGTTATAGCCCGCGGCGCAATAGGGCCCGCCTGGACCGAGGTCTGCGCATTTGCTCGGATGCTGGCGTAATGGCCCCAAGCGGCCCGTCTTGAAACACGGACCAAGG >UAMH08520_GU980696_SSU TAAAAGTCGTAACAAGGTTTCCGTAGGTGAACCTGCGGAAGGATCATTACAAGTTGAAACGGTTGCCCTCGCGGTGACCGGTTCTTCAAACCTCTGCGTACCAAACCTTTCAGTTGCCTCCGGCGGCCCTGGGCCGACGCGGCGCGCGACCTCCCCTTCGCGGGGGGGCCGCTCCTCGCGGCGGACCACCCGCCGGGCGGTCATAAACAAAACCTTTTTGTCGAGATGGCATCGTCTAATTTCTTCATAACAAAATATGAAATACAACTTTTAACAATGGATCTCTTGGCTCCGGCATCGATGAAGAACGCAGCGAAATGCGATAACTAGTGTGAATTGCAGATTTCAGTGAATCATCGAGTCTTTGAACGCACATTGCGCCTCTTGGTATTCCTCGAGGCATGCCTGTTCGAGCGTCGTTACGCCCCTCAAGCGCAAGCTTGGTGTTGGGGATCGCCCCTGAGATACGGCGGCGGCCCTTAAATGCATCGGCGGTGCTGGTGTCAGCCCGGAGCGCAGCAGACATGCGGCTTCCAGGCGACCACGCGCCCGCCGGACAACGACCCGACTTTCAAACGTCGACCTC |
IMAGES: